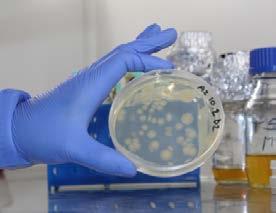

![]()







En horas de la noche de este miércoles, en el contexto de un rápido y estratégico actuar policial.
Carabineros de la 4ta.Comisaría de Cauquenes en circunstancias que desarrollaba despliegues policiales y de seguridad por la comuna, son alertados de un procedimiento de conducción temeraria por parte de un móvil, desde el que realizaba disparos; en este contexto, los funcionarios policiales, se percataron de la presencia de un individuo adulto, que conducía el vehículo, por lo que se inició un seguimiento a distancia.
Pocos minutos pasaron, cuando el conductor colisiona a otros automóviles en su escape, para posteriormente estrellarse contra un árbol.
Tras lo sucedido él conductor descendió del móvil y golpeó con una especie
que mantenía en sus manos a un funcionario de la Institución Policial y luego, lo apuntó con un elemento con características de arma de fuego corta con la que, además, intimido en reiteradas ocasiones a otros Carabineros presentes en el lugar; generándose un accionar entre Carabineros y el delincuente, quien hace caso omiso a las instrucciones entregadas. En base a lo ocurrido, Carabineros uso su arma de servicio, percutando dos disparos, sin lesiones.
En este sentido, el individuo trata de sustraer un vehículo rojo que circulaba por el lugar, ocasión en la que también amedrentó a terceras personas, con el propósito de lograr su cometido, para a continua-
ción pretender sustraer un taxi que se encontraba estacionado en un paradero; logrando en ese momento, precisamente en calle Victoria con calle Catedral, ser detenido por Carabineros, el hombre de iniciales
J.A.B.B de 19 años; se incautó un revólver, el que no estaba inscrito.
Por su parte, el Fiscal de turno instruyó remitir él armamento incautado a la Sección Especializada LABOCAR Talca y continuar con las investigaciones respectivas por parte de la Sección de Investigación Policial (SIP) de la 4ta. Comisaría de Cauquenes; por su parte el sujeto de 19 años, quién mantenía prontuario policial por diferentes delitos, fue puesto a disposición de la justicia.

El objeto es concientizar a la comunidad sobre los riesgos de utilizar estos elementos pirotécnicos, los que pueden ser fatales.

Durante estas Fiestas de Fin de Año, Carabineros de la Oficina de Integración Comunitaria de la 3era.Comisaría de Talca, liderada por el Suboficial Mayor José Luis Sepúlveda junto al Suboficial
Luis Rojas y la Sargento 2do. Roxana Sagredo y el Sargento 2do Víctor Bravo, en estos días previos a la Fiesta de Año Nuevo, refuerza el llamado a la ciudadanía, a no utilizar los fuegos artificiales; ya que el
propósito es prevenir y, evitar accidentes.
Porque los riesgos pueden ser fatales para las personas que los utilicen, como para los observadores. Si bien la venta de fuegos artificiales, está total-
mente prohibida (Ley 19.680) su comercialización ilegal existe, y en este período del año, aumenta.
En este contexto, se reitera, que los estos elementos pirotécnicos están prohibidos, tanto su mantención, utilización y comercialización.
Por su parte, el Jefe de la Oficina de Integración Comunitaria de la 3era.Comisaría de Talca, Suboficial Mayor José Luis Sepúlveda mencionó que “Como Carabineros estamos comprometidos en prevenir y, en esta oportunidad es sobre la utilización de los fuegos ar-
tificiales, la que está prohibida. En este sentido hemos desplegados amplias acciones de seguridad y autocuidado por la ciudad, para evitar su uso; ya que además de estar prohibidos por ley, pueden causar graves daños por quemaduras y, en ocasiones pueden ser fatales” dijo el Suboficial Mayor José Luis Sepúlveda. La venta al público de fuegos artificiales se encuentra totalmente prohibida y puede ser denunciada ante Carabineros por cualquier ciudadano, por medio del número de emergencia 133 o acudiendo a la unidad policial más cercana.
REPRESENTANTE LEGAL
OSCAR CASTRO ARELLANO
COLUMNISTA
OSVALDO PALMA
DIRECCIÓN
FONO: 73 2472163
YERBAS BUENAS Nº 630
LINARES
EMAIL contacto@lectoronline.cl ventas@lectoronline.cl diarioellectordelinares diario el lector
UF: $38.404,32
Dolar $989,07
UTM: $67.294,0
Juan Apóstol
Linares
13º Min. 32º Max. Despejado
Cauquenes
11 Min. 31º Max. Despejado
Todos los años realizamos un balance sobre los temas ambientales de nuestro país, para este contamos con la tercera Evaluación de Desempeño Ambiental de Chile (EDA Chile 2024) auditoría que hace la Organización para la Cooperación y el Desarrollo Económicos (OCDE) donde la primera, que fue el año 2005, fue lapidaria y evidencio la escasa gobernanza en temas ambientales del país constituyéndose años después en el Ministerio del Medio Ambiente.
Hoy estamos mejor, pero aún tenemos que avanzar en temas vitales para la calidad de vida. Del análisis de los compromisos, se realizaron 36 recomendaciones claves para continuar avanzando en la protección del medio ambiente. Aún tenemos varios problemas ambientales en Chile, donde las emisiones de gases de efecto invernadero GEI han seguido en alza, previéndose el no cumplimiento del objetivo de cero emisiones netas para 2050. En este aspecto ambiental también denota que la contaminación del aire sigue siendo un grave problema de salud pública, con concentraciones de material particulado (MP2.5) entre las más altas de la OCDE, lo que hace que las afecciones respiratorias en los percentiles más afectados, niños, personas mayores y personas con enfermedades sean las más perjudicadas.
Un tema que vivimos, en especial las personas que habitamos la comuna de Santiago, es la falta de gestión de residuos, que es nula o ineficiente, con una baja tasa de reciclaje y una alta dependencia de los rellenos sanitarios u otros lugares como vertederos clandestinos que usan ríos y otros humedales para verter estos desechos. Otro tema vital para la vida, es el agua, Chile aún enfrenta una grave crisis hídrica, con una mega sequía de 14 años y una sobreexplotación de los recursos hídricos, donde aún se evidencia la falta de normas de calidad y vertidos de aguas residuales insuficientemente regulados.
No obstante, también el documento destaca aspectos positivos como que el 27% del suministro total de energía proviene de fuentes renovables, superando el promedio de la OCDE. Después de 11 años Chile ha creado el Servicio de Biodiversidad y Áreas Protegidas y está en condiciones de alcanzar sus objetivos en materia de biodiversidad. Ha ratificación del Acuerdo de Escazú, acuerdo que promueve el acceso a la información, la participación ciudadana y la justicia en asuntos ambientales. Como país se está incentivando la emisión de bonos verdes sostenibles y con enfoque social, representando aproximadamente el 30% de toda la deuda soberana. Estos avances muestran el compromiso de Chile con la mejora de su desempeño ambiental y la adopción de políticas sostenibles.

Jadille Mussa Académica Arquitectura del Paisaje, U.Central
• Transportes y Carabineros también reforzarán medidas para asegurar tranquilidad a la ciudadanía.

TALCA.- Con especial foco en la sensibilización y prevención SENDA presentó la campaña “El Otro Plan”, con una serie medidas y actividades de autocuidado en espacios públicos, terminales de buses y otros.
Con la idea fuerza que “en estas fiestas hay muchos planes, pero el más importante es cuidarse”, la iniciativa está dirigida a automovilistas, a fin de promover la responsabilidad de no consumir alcohol u otras drogas antes de conducir y fomentar la planificación para garantizar la seguridad de todos y todas.
También a familias, padres, madres y adultos cuidadores, con la idea de involu-
directora regional de SENDA, Ana María Rodríguez. En el terminal de buses de Talca y junto a autoridades de Seguridad Pública, Transportes y Carabineros, se puso en marcha un plan especial del programa Tolerancia Cero, que considera un reforzamiento de los operativos preventivos de alcohol y otras drogas en la conducción entre el 24 de diciembre y el 1 de enero. El seremi de Transportes, Guillermo Ceroni, informó que en las fiestas de fin de año del 2023 en el Maule hubo tres personas fallecidas y 72 lesionados de diversa consideración “y no queremos que esto se repita. Por eso la fiscalización es fundamental, porque podemos constatar las condiciones de los conductores y estado de las máquinas. Hacemos un llamado a la buena conducción”.


crarles en la prevención del consumo de alcohol en niños, niñas y adolescentes, reforzando su rol como ejemplo de la conducta de otros y otras.
Y finalmente a jóvenes mayores de 18 años, para fomentar una cultura de autocuidado, enfocándose en la gestión de riesgos asociados al consumo de alcohol.
“Las fiestas de fin de año son para celebrar y compartir, siempre cuidándonos, porque lo más importante es que todos y todas lleguemos bien al 2025. Sabemos que todos y todas tienen grandes planes para estas fiestas, pero el más importante, El Otro Plan, es cuidarse”, resaltó la
“Nuestro llamado es al autocuidado y la responsabilidad durante estas fechas especiales”, complementó la coordinadora regional de Seguridad Pública, María José Gómez.
A su vez, el capitán Diego Brante, jefe de la SIAT Maule, indicó que la institución está desarrollando el plan “Navidad Segura”, que considera fiscalización en lugares de mayor aglomeración de público; control de tránsito y reforzamiento del plan cuadrante. Agregó que durante estos días, se espera que por la región circulen cerca de 200 mil vehículos.
José Manuel Vera, administrador del terminal de Talca, indicó que el mayor flujo de pasajeros se espera ocurra desde la misma tarde de ayer y que se han adoptado medidas de seguridad para prevenir delitos.



Hoy, durante un emotivo desayuno, hemos reconocido a un líder deportivo ejemplar: Patricio Valdivieso Castro, quien ha sido nombrado con orgullo Mejor Dirigente Deportivo de la Región del Maule por la Universidad Autónoma de Chile.
Este prestigioso galardón es un reflejo del compromiso incansable de Patricio con el desarrollo del deporte en nuestra ciudad.
Su labor ha beneficiado a innumerables deportistas y ha fortalecido nuestras comunidades, dejando una huella imborrable en el pa-
norama deportivo local y regional.
El liderazgo y dedicación de Patricio son un ejemplo inspirador para deportistas, dirigentes sociales y deportivos por igual. Con una trayectoria que abarca décadas, su influencia en el vóleibol linarense es digna de admiración.
La historia del vóleibol en Linares comenzó hace 40 años con la visión del exmarianista Juan Arroyo Núñez. Desde entonces, Patricio, miembro de la Generación Dorada del Instituto Linares, ha pasado de ser un destacado jugador a convertirse en un dirigente clave que impulsa este deporte a nuevas alturas.
A través de este reconocimiento, también rendimos homenaje a todos los dirigentes sociales, culturales y deportivos que contribu-

yen al crecimiento de nuestra ciudad. En especial, a quienes, como Patricio, han llevado a Linares a ser un referente en el ámbito regional, nacional e internacional.
Patricio Valdivieso Castro, nuestra admiración
y respeto por ser un pilar del deporte en la Región del Maule y un digno representante del espíritu deportivo de Linares. ¡Felicidades por este merecido reconocimiento en el año 2024!, expreso Mario Meza Alcalde de Linares

Con el firme propósito de proteger los recursos naturales y garantizar la seguridad de los vecinos, recientemente se llevó a cabo una trascendental reunión
de trabajo en dependencias de la Ilustre Municipalidad de Retiro, encabezada por el alcalde Rafael Ramírez
Parra. La instancia tuvo como objetivo coordinar
y planificar acciones conjuntas para la prevención de incendios forestales, un desafío clave en esta temporada.
En la reunión participa-
ron actores relevantes del ámbito público y privado, entre ellos:
Encargado de Emergencia Comunal.
Red de Prevención Comunitaria.
Compañía Manufacturera de Papeles y Cartones (CMPC).
Forestal Vista Hermosa.
Corporación Nacional Forestal (CONAF).
Durante la jornada, se discutieron estrategias orientadas a la prevención y mitigación de incendios, destacándose la importancia de fortalecer la capacitación comunitaria, implementar planes de emergencia efectivos y fomentar la colaboración interinstitucional para una
respuesta ágil y oportuna. El alcalde Rafael Ramírez Parra subrayó la relevancia de esta articulación: “La coordinación entre el sector público y privado es fundamental para enfrentar los riesgos asociados a los incendios forestales. Desde nuestra administración, estamos comprometidos en liderar estos esfuerzos preventivos que salvaguarden nuestro entorno natural y la calidad de vida de nuestros vecinos.”
Este esfuerzo conjunto reafirma el compromiso de la Municipalidad de Retiro con la seguridad y el bienestar de la comunidad, destacando la relevancia de la planificación y el trabajo anticipado para evitar emergencias.
• Tres fueron los instrumentos que puso a disposición órgano colegiado a pymes de las treinta comunas de la región: Activa Inversión, Innova Región y Súmate a Innovar.

El Comité de Desarrollo Productivo Regional (CDPR) de Corfo, celebró su última sesión del 2024 con resultados destacados en la ejecución de iniciativas clave para el fomento del emprendimiento y la innovación en la región del Maule. En esta instancia, se ratificó el alto nivel de ejecución de programas: “Activa Inversión”, “Súmate a Innovar” e “Innova Región”, instrumentos que la Corporación de Fomento de la Producción, dispuso a este órgano colegiado para contribuir a mejorar la productividad y competitividad de las pymes del Maule.
Uno de los aspectos más relevantes de esta última sesión fue el énfasis que los consejeros del comité destacaron es la descentralización de los procesos, lo cual
permitió que actores de diferentes sectores –públicos, privados y de la academia– trabajaran de manera conjunta para asignar los instrumentos de apoyo más adecuados para la región. Esta colaboración intersectorial ha sido clave para asegurar que las iniciativas se alineen con las necesidades y características específicas del territorio, potenciando el desarrollo de proyectos innovadores.
Sara Ramírez, directora ejecutiva del CDPR explicó los tres instrumentos que Corfo priorizó: “Activa Inversión”, dirigido a impulsar la inversión y emprendimientos de alto impacto, “Súmate a Innovar”, que promueve la colaboración entre empresas y centros de investigación para generar nuevas soluciones tec-
nológicas e “Innova Región”, que busca fortalecer el ecosistema regional de innovación, continúan demostrando su relevancia y efectividad. Estas iniciativas han logrado dinamizar la inversión y fortalecer el espíritu emprendedor, contribuyendo al crecimiento de sectores estratégicos a nivel regional como: silvoagropecuario, agroindustria, industria 4.0, turismo”.
“El éxito de estos programas refleja el compromiso de todos los integrantes de este comité por impulsar un ecosistema de emprendimiento e innovación que sea inclusivo y accesible para todas las comunas de nuestra región del Maule. A través de la descentralización de estos procesos, hemos logrado involucrar a diversos actores, lo que enriquece las decisiones y asegura una mayor pertinencia y efectividad de los instrumentos. Hoy, podemos ver resultados tangibles en la activación de inversiones y en el fortalecimiento de la innovación en diversas comunas”, señaló Cristina Bravo, gobernadora y presidenta del CDPR.
El CDPR, como órgano colegiado, continuará desempeñando un rol fundamental en la evaluación y selección de proyectos, asegurando que los esfuerzos de Corfo sigan alineados con las tendencias globales de innovación y con las necesidades específicas de la región.
Acerca de Corfo
Corfo es el organismo del Estado encargado de promover la innovación, el emprendimiento y la competitividad en Chile, apoyando a las empresas en su proceso de crecimiento, expansión y modernización. A través de sus programas, busca impulsar el desarrollo económico de las regiones del país, apoyando a la creación de empleos y el fortalecimiento de la infraestructura productiva.
Desafíos 2025
Con miras al futuro, se presentaron los principales desafíos para el año 2025, con énfasis en la necesidad de potenciar sectores productivos clave, como la agricultura, la industria del turismo, agroindustria e industria 4.0, así como en fortalecer la infraes-
tructura regional y las capacidades locales para impulsar la innovación. La sustentabilidad y la digitalización también se perfilan como ejes fundamentales para garantizar un desarrollo resiliente y competitivo en los próximos años.
Compromiso con el desarrollo territorial
La directora ejecutiva del CDPR señaló que “la colaboración y el trabajo conjunto entre todos los actores del territorio son fundamentales para impulsar una verdadera transformación productiva. En estos cinco meses hemos avanzado mucho, pero sabemos que aún hay desafíos por delante. Estamos comprometidos con un Maule más próspero y descentralizado”, aseguró Sara Ramírez.
La sesión concluyó con un llamado a seguir fortaleciendo los lazos entre los diversos actores, asegurando que el desarrollo regional se base en una visión compartida que impulse el crecimiento económico y el bienestar de todos los habitantes de la Región del Maule.
Cómo combatir el calor extremo sin depender solo del agua: técnicas
Se prevé que las altas temperaturas persistirán en varias regiones del país durante el fin de semana, superando los 33 grados. Por ello, recurrir a estrategias complementarias para mantenerse hidratado, además de consumir agua, puede ser fundamental para evitar complicaciones asociadas a las olas de calor.
Para el Dr. David Torres, académico de la Facultad de Medicina UANDES, lo más eficiente es usar agua fría en lugares estratégicos; por ejemplo, se pueden poner compresas frías como paños húmedos en la parte detrás del cuello, las muñecas, axilas, detrás de las rodillas o la ingle que son lugares donde hay un mayor
flujo sanguíneo por lo tanto es más fácil tener la sensación de frío en el resto del cuerpo. El académico, también explica que se puede humedecer la piel ligeramente y exponerse al viento con un ventilador, eso hace que el calor que está dentro del cuerpo salga más rápido y se enfría rápidamente. Una ducha corta con agua fría también es útil y un atomizador de agua fría también puede servir.
Por último, en cuanto a la ropa, el lino es una excelente opción para combatir las altas temperaturas. “Este material es altamente transpirable, facilita la evaporación del sudor y, al ser liviano, reduce la acumulación de calor
corporal. Si además eliges prendas de colores claros, el beneficio es aún mayor, ya que reflejan la luz del sol. También puedes refrescarte sumergiendo los pies en agua fría, usando sombreros húmedos, sombrillas y optando por ropa clara en general, lo que ayuda a disminuir la sensación de calor”, finaliza Torres.
• Atenderá a 30 mil usuarios de los sectores Villa Francia, Doña Ignacia y Doña Antonia.
• Las obras avaluadas en más de 10 mil millones de pesos, deberían concretarse a finales del 2025. El proyecto financiado íntegramente por el Gobierno Regional del Maule, contempla todos los equipamientos para que funcione el recinto de salud.
La Gobernadora Regional del Maule, Cristina Bravo, la delegada presidencial regional (s) Aly Valderrama, el alcalde de Maule, Pablo Luna y el subdirector del Servicio de Salud del Maule, Cristian Rosales, recorrieron las obras del Cesfam Maule Norte, que alcanza el 17% de avance.
Ubicado en calle Duao, entre 4 y 5 poniente, el nuevo recinto de salud, brindará una atención a miles de habitantes de la comuna de Maule, que habitualmente se desplazan hasta Talca tanto por la cercanía, como por la saturación de los recintos de salud públicos disponibles en los alrededores.
Cristina Bravo Castro, gobernadora regional, valoró el avance de las obras, tanto de este Cesfam, como de los otros 4 que ha impulsado durante su gestión, “para nosotros es muy importante, lo que hemos avanzado en conjunto con el SSM, en el emplazamiento de estos proyectos. Este era un proyecto muy necesario que veníamos trabajando con el ex alcalde de Maule y con el actual alcalde Pablo Luna, porque era muy necesario contar con un nuevo Cesfam que pueda dar respuesta a los requerimientos que tienen los vecinos de este sector”. En tanto, el subdirector de recursos físicos del Servicio de Salud del Maule, detalló, “este es un Cesfam que viene a resolver una brecha de cobertura que tiene la comuna de Maule, esta pensado para atender a 30 mil perso -
nas de todo el sector norte de Maule, tiene 2700 m2 aproximadamente de obras, con una distribución de 3 sectores desde la perspectiva de la salud familiar”. Además, aseguró que según el cronograma debería estar listo para fines de 2025.
El Alcalde de Maule, Pablo Luna, agradeció la voluntad política de la Gobernadora Regional y el Consejo Regional en pleno, por el financiamiento del proyecto y sostuvo estar, “de verdad feliz por este avance de este tremendo Cesfam, decirle también a los vecinos que el dispositivo que esta acá, de Maule Norte, no lo vamos a cerrar, eran muchas las consultas de que si íbamos a cerrar el dispositivo que está en la Doña Antonia, al contrario, lo vamos a potenciar”.
La delegada presidencial regional (s), Aly Valderrama, expresó que “estamos dando cuenta de que el estado de avance de esta obra se encuentra en un 17%, lo que va a permitir a los vecinos tener la certeza de que van a poder contar con este tipo de atención en un tiempo bastante reducido, entendiendo además que puntualmente en esta zona, existen 30 mil personas que requieren atención. Esta es una forma de cómo el trabajo mancomunado entre el sector público, el Gobierno Regional, los municipios y entre todos, podemos generar la inversión pública para mejorar las condiciones de vida de las vecinas y vecinos de este sector”.



En el encuentro se realizó un saludo protocolar al nuevo alcalde y se revisaron las iniciativas financiadas Subsecretaria de Desarrollo Regional y Administrativo (Subdere) en la comuna y los futuros proyectos para su mandato.
Hasta San Rafael llegó el encargado de la Unidad Regional Subdere (URS) del Maule, Hugo Silva Lemus, para reunirse con el nuevo alcalde de la comuna, Basilio Pérez, con quien sostuvo una primera reunión protocolar y analizar la cartera de proyectos financiados e informar sobres las iniciativas y programas Subdere. Por otro lado, las autoridades conversaron sobre futuros proyectos que se impulsarán desde el municipio de San Rafael y cuál será la dirección y lineamientos de la actual administración. También, se mostró muy dispuesto a trabajar mancomunadamente con Subdere para llevar financiamiento a su comuna, ya que hay grandes desafíos y se trabajará pensando en el desarrollo comunal y en el bienestar
de las vecinas y vecinos de San Rafael.
El encargado regional de Subdere sostuvo que “estuvimos conversando sobre algunas líneas de Programa de Mejoramiento Urbano, como mejorar algún equipamiento deportivo, juntas de vecinos, etc. También se conversó sobre el financiamiento del Programa Mejoramiento de Barrios, para ver especialmente temas sanitarios. Y finalmente, hablamos sobre el Programa de Tenencia Responsable de Animales de Compañía, respecto a ver algún proyecto que tenga relación a las esterilizaciones de perros y de gatos de vecinos de la comuna”.
“Levantaremos una cartera de proyectos robusta y en ese sentido la labor
que realiza la Subdere es tremendamente importante para comunas pequeñas como la nuestra, donde los proyectos que
desarrollamos y que son emblemáticos obedecen a financiamientos externos al presupuesto municipal, de ahí la relevancia de
esta reunión y de mantener una comunicación estrecha con este servicio público”, destaco el alcalde Pérez.


El 26 de diciembre, informamos que el incendio activo en la provincia de Cauquenes cuenta
con la intervención de personal de CONAF de Maule y Ñuble, así como recursos de la empresa
Arauco Vista Hermosa y dos brigadas Brife del Ejército de Chile. Además, se prevén con -
diciones meteorológicas adversas en el Maule, como intensas marejadas en la costa y altas temperaturas desde el 26 hasta el 29 de diciembre, afectando el litoral, el valle central y la cordillera. Estas condiciones podrían dificultar el control de cualquier foco de incendio. Aunque contamos con personal comprometido de CONAF y empresas privadas, es crucial que la sociedad entienda la gravedad de la situación.
Es importante recordar que la ley sobre incendios vigente en nuestro país estipula penas de cárcel para quienes utilicen fuentes de calor
que provoquen incendios. Recientemente, se condenó a una persona en Pelluhue a prisión efectiva por un incendio, y en San Javier, el responsable del siniestro está detenido actualmente.
La comunidad debe unirse para enfrentar este problema. Cuidémonos entre todos. También lamentamos este año las muertes por accidentes automovilísticos. La seguridad es un esfuerzo colectivo; todos somos agentes de seguridad y debemos trabajar por nuestra comunidad para despedir un feliz 2024 y recibir un próspero 2025.
El Centro de Estudios y Alimentos Procesados (CEAP), representado por su directora y su gerente de innovación, finalizó recientemente una fructífera Gira de Innovación por Europa 2024, con el objetivo de explorar nuevas tecnologías y oportunidades que permitan agregar valor al sector agroindustrial de la Región del Maule. Esta gira, organizada con el apoyo de FIA y el Gobierno Regional del Maule, incluyó la participación de representantes de destacadas agroindustrias regionales como Productos Fernández, Surfrut, Mostos del Pacífico y Agrozzi.
La gira comenzó en París, donde la delegación participó en la SIAL 2024, una de las ferias alimentarias más importantes del mundo, con más de 7.000 expositores de más de 100 países. Durante el evento, se exploraron tendencias globales, innovaciones en el sector de alimentos y oportunidades para posicionar los produc-
tos del Maule en mercados internacionales.
Además durante este recorrido, que requirió una planificación detallada y una intensa coordinación de agendas, la delegación chilena sostuvo reuniones clave en diversos puntos de Europa, destacando las siguientes visitas:
√ INGELIA: se conoció una tecnología única a nivel global para el procesamiento de residuos, que permite su transformación en carbón, contribuyendo al desarrollo sostenible y la economía circular.
√ PAHÍ: empresa líder en la producción y distribución de productos tartáricos, derivados del proceso de elaboración del vino, cuyas aplicaciones son clave en la industria alimentaria.
√ LUCTA: En esta compañía especializada en fragancias, aromas y aditivos para productos de nutrición animal.
√ IRTA (Instituto de Investigación y Tecnología
Agroalimentarias): Se pudo conocer parte de sus estrategias para impulsar la investigación y el desarrollo tecnológico en el sector, para desarrollar la transferencia de avances científicos y fomentar la colaboración entre los sectores público y privado.
√ CNTA (Centro Nacional de Tecnología y Seguridad Alimentaria): Un Centro con un modelo de membresías para sus socios y con una presentación de servicios especiales para las necesidades de las empresas locales y que cuenta con capacidades fundamentales para elevar la competitividad de las empresas regionales en materia de alimentos.
√ FI Group: Se conoció la diferenciación de uso de los incentivos fiscales para la I+D+i en España y Chile, se mostraron ejemplos de proyectos agroindustriales de empresas que presentaron a la administración local sus propuestas, y a través de la certificación de

dichas iniciativas, lograron rebajar el impuesto a pagar a Hacienda, por el uso de esta herramienta. Un ejemplo de política publica que beneficia la inversión en I+D+i. Esta gira fue clave para generar alianzas estratégicas orientadas al desarrollo sostenible de la agroindustria del Maule entre los integrantes del grupo. La experiencia fue intensa, pero las ideas y planes que surgieron esperamos que marquen un antes y un después en el camino de la agroindustria de la región del Maule.
Nueva convocatoria
Hasta el 9 de enero se encontrará abierta la Convocatoria
Regional de Instrumentos
Complementarios 2025 de la agencia FIA que busca fomentar la innovación en los sectores agroalimentario y silvoagropecuario. Se podrán apoyar aproximadamente 15 instrumentos de la región.
La propuesta incluye tres líneas de apoyo diseñadas para fortalecer el desarrollo de innovaciones: Consultorías, Eventos y Giras para la innovación.
CampoLimpio cerró exitosamente las actividades de recolección móvil del año 2024 con la realización de su último Punto Móvil en la comuna de Pichidegua, Región de O’Higgins, en donde participaron más de 50 agricultores y agrícolas. Durante la jornada, se recolectaron 32.136 envases plásticos vacíos, previamente sometidos al proceso de Triple Lavado, alcanzando un total de más de 10 toneladas de material reciclable.
CampoLimpio, el primer y único sistema de ges -
tión de envases agroindustriales autorizado por el Ministerio del Medio Ambiente bajo la Ley de Responsabilidad Extendida del Productor (REP), contribuye con esta actividad al cumplimiento de esta normativa, la cual exige que las empresas que comercializan productos prioritarios organicen y financien la recolección y reciclaje de los envases generados, y además establece la obligación para los agricultores de realizar el Triple Lavado de los envases vacíos
y entregarlos en sistemas de gestión autorizados, promoviendo la economía circular y reduciendo los impactos ambientales. Con una red consolidada por más de 30 centros fijos y 109 puntos móviles en todo el país, CampoLimpio ya se encuentra planificando las próximas jornadas de recepción de envases que se realizarán durante los primeros meses de 2025 y serán informadas oportunamente a través de www.campolimpio.cl y sus redes sociales.

• En un seminario-taller investigadores presentaron los avances de un innovador proyecto que utiliza levaduras nativas para mejorar la conservación de frutos no climatéricos. Productores locales y autoridades dialogaron sobre las necesidades de la industria, destacando el impacto positivo de esta iniciativa en la calidad y comercialización de la frutilla.

Como parte del proyecto “Sistema de conservación, basado en una levadura nativa mejorada con óptima producción y liberación de un gasotransmisor natural, para alargar la vida útil de frutos carnosos no climatérico”, se realizó un seminario-taller en las dependencias del INIA La Cruz donde investigadores compartieron los avances y alcances de esta iniciativa con agricultores, productores locales y autoridades municipales.
Esta iniciativa es dirigida por el Dr. Sebastián Molinett, investigador del INIA La Cruz y es financiada con aportes de la Agencia Nacional de Investigación y Desarrollo (ANID), Subdirección de Investigación Aplicada (SIA). Este estudio es ejecutado en conjunto con la Universidad de Santiago donde participa el académico Claudio Martínez, PhD en Biología con especialización en genética y la participación como empresa asociada de Agro Q-Tral, potencial licenciataria de la tecnología.
El evento, organizado por INIA La Cruz para fomentar el diálogo entre la investigación científica y el sector productivo, reunió a productores integrantes de Agrofrutilla San Pedro, usuarios de los Prodesales y representantes del Departamento Agrícola Municipal de la Municipalidad de San Pedro.
El seminario comenzó con una charla acerca de la presentación general del proyecto y sus alcances, la cual fue dictada por el Dr. Sebastián Molinett, investigador del INIA La Cruz, donde se destacaron los objetivos y los avances logrados hasta la fecha.
Esta charla inicial fue seguida por la exposición del Dr. Carlos Figueroa, profesor
de la Universidad de Talca y miembro del equipo técnico, quien abordó herramientas biotecnológicas para el manejo postcosecha, enfocándose en la mejora de la vida útil de la frutilla y la calidad del fruto. Según el Dr. Figueroa “este proyecto busca integrar años de investigación en frutillas comerciales, blancas y chilenas, desarrollando alternativas biológicas efectivas que permitan mejorar la calidad y la conservación del fruto, adaptándonos a las necesidades de los agricultores y a las variaciones climáticas locales.”
Posteriormente, se llevó a cabo un conversatorio con los asistentes, generando un espacio para compartir ideas, sugerencias y observaciones. Estas contribuciones serán fundamentales para ajustar las próximas etapas del proyecto, el cual se extenderá hasta 2025.
“El avance de la biotecnología en la agricultura está abriendo nuevas posibilidades para los productores de frutales y hortalizas”. Sebastián Molinett, experto en innovación biotecnológica, destacó la necesidad de investigar sobre estas técnicas que permiten mantener la frescura de la fruta por más tiempo, minimizando pérdidas y optimizando la comercialización. “Con la aplicación de estos avances, la industria podría reducir significativamente el desperdicio de este producto tan demandado, beneficiando especialmente a los pequeños y medianos productores.”
Testimonios
Roberto Farías, representante de Agrofrutilla San Pedro “La vida útil de la frutilla es un gran desafío, especialmente en verano. Este proyecto promete triplicar su duración, lo que será revolucionario para nues-
tra producción y comercialización.”
Nancy Villagra, encargada del Departamento Agrícola Municipal
“Esta iniciativa permitirá llevar al mercado frutillas de mayor calidad y duración, beneficiando directamente a nuestros productores locales.”
Juan Pablo Pazzi, productor de Nihué Alto
“Ser parte de este proyecto desde sus inicios nos brinda la oportunidad de mejorar significativamente el estado de nuestras frutillas frescas al llegar a los consumidores.”
Proyección y relevancia
Chile, aunque es un actor menor en el panorama mundial de la producción de frutillas, destaca por la calidad de su fruta. Este proyecto busca posicionar al país mediante soluciones innovadoras, como el uso de biotecnología, para extender la vida útil del fruto y reducir pérdidas en postcosecha.
El seminario marcó un importante hito de colaboración entre la academia, los productores y las autoridades locales, abriendo camino para futuras actividades en terreno y consolidando la relación con el sector agrícola en la comuna de San Pedro.
En qué consiste el proyecto Este proyecto liderado por INIA, se ejecuta en conjunto con la Universidad de Santiago quienes cuentan con un pool de 195 cepas de levaduras nativas de Saccharomyces cerevisiae, que tienen la capacidad de producir gasotransmisores. El equipo de investigación y desarrollo de la Universidad de Santiago es liderado por el Dr. Claudio Martínez Fernández, PhD en Biología con especialización en genética.
La académica de la UCM, Radha Devi Pyarasani, elabora un hidrogel agrícola, que se descompone a través de un proceso natural y libera nutrientes de manera controlada.

Un notable avance para la industria agrícola representa un hidrogel que desarrolla una investigadora de la Universidad Católica del Maule, en el marco de un proyecto financiado por el Fondo de Innovación para la Competitividad (FIC). Se trata de una prometedora herramienta tecnológica que además de optimizar el uso de agua en cultivos, es biodegradable.
“En el mercado existen productos tradicionales que son sintéticos, pero en nuestro caso estamos elaborando un hidrogel en base a biopolímeros que son biodegradables y amigables con el medio ambiente”, anunció Radha
Devi Pyarasani, académica del Centro de Investigación y Estudios Avanzados del Maule (CIEAM), perteneciente al plantel. Creado a partir de resinas de árboles como pino radiata y liquidámbar, y de residuos agroalimentarios, el hidrogel se desintegrará por un proceso natural biológico.
“La idea es aportar soluciones innovadoras a la sequía en la región. Gracias a la acción de polímeros, la estructura tendrá la capacidad de absorber y retener grandes cantidades de agua o fluidos, sin disolverse, incorporándose directamente en la zona radicular de las plantas. El recubri-
miento actuará como una barrera que evita el ‘efecto explosión’”, precisó la doctora en Ciencias.
Pyarasani, quien lleva seis años trabajando en la línea de nanomateriales, explicó que el compuesto será capaz de liberar fertilizantes de manera gradual y controlada, en sincronía con las necesidades metabólicas del cultivo. “Pensamos que el hidrogel puede funcionar sobre todo en hortalizas como tomates y frutillas, y en productos frutícolas como cerezas. Tenemos que hacer el estudio en el campo, en el suelo; estamos muy emocionados por empezar este trabajo”, sostuvo.
Redes internacionales
Revolucionar la agricultura moderna, facilitando el crecimiento de plantas saludables, con uso reducido de agua, también generó expectativas en la Agencia Nacional de Investigación y Desarrollo (ANID), que destinó recursos para potenciar el análisis global del hidrogel.
“Nos adjudicamos un proyecto FOVI-ANID para hacer vínculos con universidades extranjeras, como el Instituto de Investigación Agrícola de la India (IARI), adonde viajará un alumno del Doctorado de Biotecnología Traslacional de la universidad, para probar
los materiales que preparamos aquí y ver si son efectivos y se pueden comercializar. La red de colaboración interregional e internacional facilita la creación de programas de formación conjuntos, intercambios académicos y la publicación de investigaciones, lo que impactará directamente en el prestigio y la visibilidad de la UCM a nivel internacional”, indicó. Por medio del concurso “Fomento de Vinculación Internacional”, el proyecto contribuirá a la capacitación de recursos humanos, que igualmente realizarán programas de instrucción y pasantías en la Universidad de Qatar.
La relación entre ambas y su manejo adecuado es crucial para la calidad de vida de los pacientes.
La relación entre la diabetes y las enfermedades periodontales es crucial, ya que ambas patologías crónicas pueden influirse mutuamente. La académica de la Escuela de Odontología de la Universidad de Talca, Claudia Descouvieres, explicó la importancia de este vínculo y las medidas que se pueden tomar para su manejo.
“La diabetes es una enfermedad sistémica, lo que significa que afecta a todo el cuerpo, incluyendo el sistema de
defensa, lo que puede complicar la respuesta a infecciones”, comentó la especialista. En pacientes con diabetes descompensada, esto puede resultar en una enfermedad periodontal más severa, con mayor riesgo de pérdida ósea, movilidad dental y sangrado de encías.
Cabe recordar, que las enfermedades periodontales aparecen por una infección crónica de las encías, y que pueden llevar a la pérdida de piezas dentales y comprome-
ter negativamente el hueso donde se apoyan los dientes. Dicha patología, además, puede complicar el control de la glucosa en pacientes diabéticos. “Las infecciones periodontales liberan mediadores biológicos en el torrente sanguíneo, dificultando el control de los niveles de glucosa”, indicó Descouvieres. También resaltó que, en muchos casos, los odontólogos son los primeros en detectar síntomas de diabetes en pacientes debido a la ma-
nifestación de enfermedades periodontales.
Control y prevención
Es crucial que los pacientes diabéticos mantengan un control regular con su dentista para monitorear su salud oral. Esto incluye la evaluación de lesiones de la mucosa oral, caries y enfermedad periodontal. “Un control adecuado de las enfermedades periodontales puede facilitar un mejor control de la diabetes”, enfatizó la académica.
La doctora Descouvieres recomendó a los pacientes diabéticos seguir rigurosamente sus controles médicos y dentales. “Ambos tipos de enfermedades requieren de un manejo continuo, por lo que es vital que los pacientes asistan a controles periódicos para prevenir complicaciones mayores”, señaló. La frecuencia de estos controles dependerá del riesgo y el estado de control metabólico de la diabetes.
Como ya es tradición, el Comité de Navidad “Bárbara Fuentes Yáñez” del Hospital Regional de Talca (HRT) ha llevado alegría y esperanza a pacientes y funcionarios durante las fiestas de fin de año. Conformado por funcionarios de distintas áreas y estamentos del hospital, los miembros del Comité han demostrado un gran compromiso y dedicación a través de tres líneas de trabajo principales -decoración, intervenciones musicales navideñas y la entrega de regalos a pacientes hospitalizados-, logrado así transformar los espacios hospitalarios gracias a la promoción de un ambiente cálido, acogedor y lleno de espíritu navideño.
La decoración de los accesos principales es una de estas líneas de trabajo, resultado de una labor minuciosa, realizada con el objetivo de crear un ambiente festivo y lleno de color.
“Nosotros trabajamos todo el año, planteamos ideas de los sectores que podríamos nosotros decorar, es un sacrificio personal, muchas veces también de la familia de nuestros funcionarios, para hermosear las distintas entradas del hospital” afirmó Rodrigo Bäuerle, presidente del Comité.
Por otra parte, La presencia de orquestas y coros ha sido otro de los pilares del trabajo realizado por este Comité del HRT. “La gran mayoría se da el tiempo de parar, escuchar, aplaudir, ya que estas instituciones sin fines de lucro se preparan para participar con nosotros a fin de año” destacó Bäuerle. Las intervenciones musicales se realizaron en el Hall de acceso principal del establecimiento, lugar que tiene la particularidad de proyectar las melodías navideñas hasta el 2do y 3er piso de la torre principal, razón por la que tanto funcionarios como
usuarios se acercan muy entusiasmados a disfrutar de los bellos conciertos desde las alturas.
Este año fueron 6 las intervenciones musicales navideñas coordinadas por el Comité:
• Coro Liceo Bicentenario Oriente de Talca
• Coro Semillita y Juvenil Liceo Santa Marta de Talca
• Coro Colegio Montessori Talca
• Orquesta de Cámara del Liceo Abate Molina de Talca
• Coro Universidad de Talca
• Ensamble de Cuerdas de la Orquesta Clásica del Maule
Presentaciones que se han destacado por su maravillosa puesta en escena y calidez al momento de presentarse en el hospital.
UN SIMBÓLICO REGALO QUE LLEGA AL CORAZÓN
Pero sin duda, la entrega de regalos a los pacientes hospitalizados ha sido el momento más emotivo.
“Cada uno de nosotros nos personificamos, tanto el Viejo Pascuero, el Reno y el Grinch, y se hacen dinámicas donde hacemos partícipes al paciente y los funcionarios, generando un ambiente bastante agradable, que los saca un poco de este mal momento o dolor que ellos sienten y les retribuimos con esta alegría “ expresó Bäuerle. La iniciativa ha sido valorada enormemente por los pacientes, como lo demuestra el testimonio de María Sanhueza: “Me parece súper bien, me parece que dan una motivación a todas las personas que estamos aquí en el hospital sufriendo por cualquier patología diferente y que dan un momento de alegría y se agradece mucho eso”.
La iniciativa no solo alegró a los pacientes, sino también al equipo de salud. TENS como Margarita Toledo, quien trabaja en el área de Alto Riesgo Obstétrico, valoraron profundamente este gesto: “Los felicito por esta linda actividad de traer alegría a las pacientes y ojalá sigan haciéndolo porque siempre es rico recibir noticias lindas y motivos navideños”. Su entusiasmo refleja el impacto positivo de estas iniciativas en el ánimo del equipo de salud, demostrando que reconocer el trabajo de todos los miembros es fundamental para mantener un ambiente laboral positivo y motivador.





